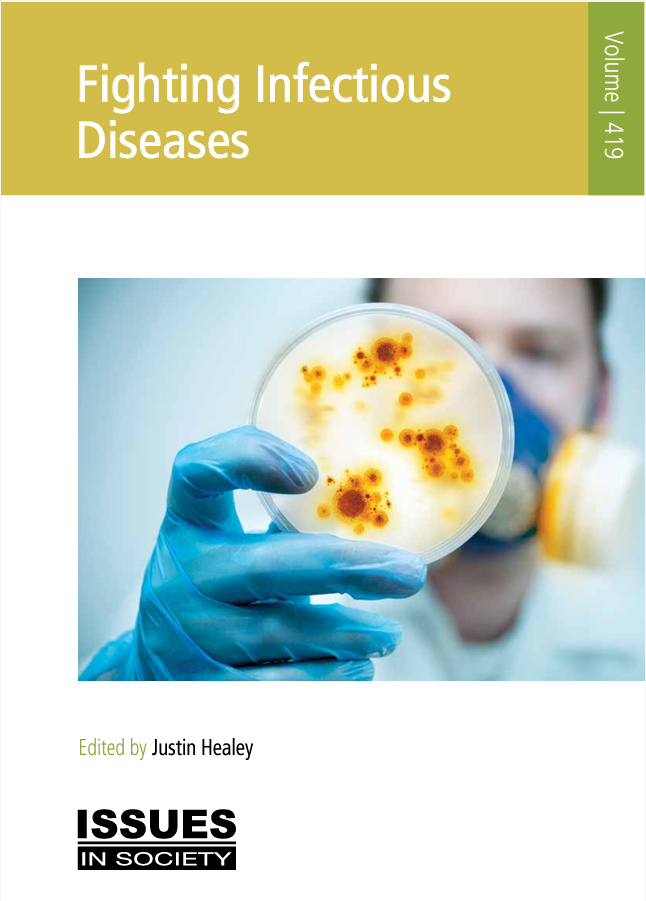

In the last three decades, obesity has increased in almost every country in the world, among adults and children alike. Globally, more than two billion people are now overweight or obese; among high-income countries, Australia and New Zealand have seen the greatest recent growth in obesity rates. This book presents an overview of Australia's national weight problem, explaining how body weight is measured and highlighting the causes, health risks and costs of overweight and obesity. General advice is also offered on how to achieve and maintain healthy weight through balanced food intake, increased physical activity, and government

According to the latest National Survey of Australian Secondary Students and Sexual Health, teenagers claim sex education in schools is inadequate and focuses too much on biology instead of issues such as the emotional challenges of relationships, sexuality diversity, pleasure and consent. This book presents the latest information on sexual and reproductive health for young people, and includes key survey findings and advice on a range of safe sex behaviours relating to teenage relationships, sexual pressures and consent, contraception choices, teen pregnancy and sexually transmitted infections. The book sensitively explores the most effective approaches to sexuality education for parents, teachers and students. How can teenagers be encouraged to learn positive sex education in the digital age?

Are you, or someone you know, experiencing low moods? One in five women and one in eight men will experience depression at some time in their life. Depression is often not recognised and can persist for months or even years if left unaddressed. Depression is treatable and effective treatments are available. Dealing with depression early can help you address problems quickly and avoid symptoms becoming worse. So what are the signs and symptoms of depression? This book examines the myths and explains the facts in relation to the major types of depression, and offers helpful general advice on diagnosis, treatment and management from trusted mental health organisations. Learn to find ways to beat the blues and deal with depression.

Food safety is the concept that food will not cause harm to the consumer when prepared and/or eaten according to its intended use. In Australia we rely on food safety standards to protect us from food-borne illness and food poisoning caused by poor handling, contamination, storage and temperature issues. Who is responsible for food safety in Australia? What can we do ourselves as cooks and consumers to minimise exposure to food poisoning? This book is a comprehensive guide featuring food safety tips on handling, hygiene and contamination. The book also explains symptoms, causes and labelling information in relation to food allergies, additives and intolerances. You are what you eat - ensure you eat food in the knowledge it is safe.

Increasingly, Australians are caring more about the origins and values of the foods they consume. This book addresses two often misunderstood agricultural production methods - organic and genetically modified food. Organic food is grown andproduced without using synthetic chemicals such as pesticides and artificial fertilisers; so what are the actual ethical, environmental and nutritional differences between organic and conventionally-produced food? Are organics healthier? Genetic modification is a science-driven crop and animal breeding method which has attracted controversy and confusion in recent years. Which foods are GM in Australia, how are they labelled and regulated, and are there any proven environmental or health-related side-effects? This book serves you up an abundance of information with which to make more informed food choices

Cancer is now the biggest killer globally. In Australia, about three in every ten deaths are caused by cancer. In Western countries, including Australia, the rise in cancer cases is attributable to ageing populations and increased screening. Lifestyle has also been highlighted as a major causal factor, with cancer particularly prevalent in countries where people have poor diets, inactive lifestyles and high smoking rates. This book presents accessible information aimed at improving understanding around the causes and prevalence of cancer, as well as offering general advice on cancer prevention and awareness. What are the risk factors for the most common forms of cancer, and what are the best approaches regarding early detection and prevention? The best cancer is the one you don not get - prevention is the greatest cure.

The gap between mainstream and alternative medicine is blurring. Complementary and alternative medicine (CAM) is widely used in Australia; increasingly, people are turning to these treatments for ailments ranging from minor conditions to life-threatening illnesses. While there are many enthusiastic proponents of alternative healing, others remain sceptical and demand scientific evidence of its success. This book explores the various techniques and therapies available, and looks at how to find a reliable CAM practitioner. The book also considers the myths and facts in the debate over the use of alternative treatments, offering differing perspectives from conventional and alternative medical practitioners and peak bodies. What are the potential benefits and harms of these therapies, and how are they regulated? What evidence is there to support the effectiveness and safety of dietary treatments such as herbal medicines and vitamin supplements? Are these medical alternatives a panacea or a placebo?

Death eventually comes to claim us all, yet most people live in denial of it until they are confronted with their own mortality. In order to ultimately have a good death - such as dying comfortably at home, supported by family and friends and effective services - discussion, decisions and planning are required to put things into place, knowing your family is acting according to your wishes. Planning for the end of ones life may entail making an advance care plan; funeral and estate planning; palliative care; understanding the legal status and complexities of voluntary euthanasia; and being prepared for what to expect during a loved ones final hours, including ensuing feelings of bereavement and loss. This book explores a range of issues for us all to anticipate and evaluate at some stage: end of life attitudes and decisions; end of life care; and coping with death and grief. What are your wishes and rights (and those of your loved ones) when it comes to the personal and practical considerations we have to deal with at the end of life?

Sugar has become ubiquitous in our modern diet in a variety of forms, and is most notably present in popular processed foods and sugary drinks. This title explains the latest consumption guidelines and data, detailing the amount of sugar added to common food and beverage items, the excessive consumption of which can lead to serious health conditions such as obesity, diabetes, tooth decay and heart disease. The book offers helpful advice on reducing unhealthy sugar intake through personal dietary behaviours such as how to identify sugars on food labels; it also presents perspectives in the ongoing debate over government policy approaches including a proposed sugar tax. How much sugar is it OK to eat, what are its health impacts, and how can we manage its consumption? Excessive sweetness has unsavoury consequences - how are you watching your sugar intake?
Infectious, or communicable, diseases are a major global health concern. Managing and preventing the spread of diseases takes a concerted public health effort to deal with deadly outbreaks, epidemics and pandemics. What are the various waysin which infectious diseases are spread? How much of a threat are emerging infections such as Ebola, SARS and the Zika virus to large populations of people? And how much of a concern is the growth in antimicrobial resistance to drugs, such as antibiotics, which are routinely used to treat infection? The World Health Organization estimates that vaccines prevent 2-3 million deaths every year; how effective has immunisation been in Australia at containing and eradicating vaccine-preventable diseases? What are the myths and facts regarding the safety and effectiveness of vaccines, and why do some misconceptions among immunisation objectors persist? This book reveals the global trends and challenges in the fight against the major types of infectious disease, and looks at vaccine-preventable diseases and immunisation in Australia. Are we doing enough to win the ongoing fight against infectious diseases?

Adolescence and young adulthood is a significant transition period in a person's life in many ways. Young people may experience challenges including a range of mental and behavioural disorders, anxiety-related conditions, depression, substance use, self-harm and suicidal behaviours. What is good mental health, and how can young people be encouraged to seek help if they are struggling? This book looks at the prevalence of mental health problems for young Australians and offers general advice on how to maintain good mental health. Tips include advice for parents and friends on how to help someone with a mood disorder, as well as options for mental health assessment, treatments and therapies for teenagers who are not coping as well as they would like. A key focus of the book is selfharm and suicidal behaviours, revealing the latest approaches to reducing youth suicide. Learn how to watch out for the warning signs, work on your mental wellbeing, and banish the blues.|Includes: Aboriginal and Torres Strait Islander people, alcohol use, anxiety, cognitive behavioural therapy, coping mechanisms, counselling, depression, diet, mental disorders, drug use, e-therapies, exercise, setting goals, professional help, seeking help, hospitalisations, medication, physical health, psychological distress, relaxation techniques, self harm, services, sleep, stigma, stress.

Only about a third of children and under half of adults are meeting Australia's Physical Activity and Sedentary Behaviour Guidelines. Most children exceed the recommended amount of screen-based activity time, while time spent sitting at leisure goes up in adults as they get older. Inactivity increases overweight and obesity, raising the risk of chronic and lifethreatening diseases like cardiovascular disease, dementia, type 2 diabetes and some cancers. Regular physical activity not only reduces health risks, it improves social and emotional health and wellbeing. Which groups of inactive Australians are most at risk of lifestyle-related illness? What levels and types of activity are required for optimal health at each life stage, and how can we incorporate regular activity into our daily lives? This book explains the risks and consequences of physical inactivity, and in turn promotes the benefits of being active. It's time to move it, or lose it.

Most people suffer from stress at some point in their lives, yet it affects people in different ways. A certain level of stress is necessary to motivate us to reach our potential, however if we experience too much stress, it can become a serious health concern. This book is a useful guide aimed at helping Australian teenagers and young people to identify and understand stress and its impacts on their mental and physical health. It features a range of tips, strategies and tools for managing and reducing stress, including relaxation techniques. This title also dedicates a chapter to handling exam stress, showing readers how to reduce stress caused by study pressures and most effectively prepare for exams. Learn how to stress less and be at your best under pressure.

Loneliness is a feeling of sadness or distress about being by yourself or feeling disconnected from the world around you, which is felt more over a long period of time. It is even possible to feel lonely in a crowd. Social isolation, on the other hand, is being separated from other people and your environment, due to either personal decisions or circumstances. Chronic loneliness is on the rise in Australia; many of us, including seemingly connected young people, lack strong and meaningful relationships to enrich our lives and protect our physical and mental health and general wellbeing. According to a recent report on loneliness, one in four Australians reported feeling lonely each week. Experts warn of a "loneliness epidemic" that could become our next public health crisis. What causes social isolation and loneliness and who experiences it? This book explores the extent and impacts of loneliness and isolation, and offers advice on how to encourage social connections so that you don't have to go it alone.

The devastating, widespread experience of COVID-19 has captured the world's attention this year, however epidemics and pandemics are not a new phenomenon. Throughout history, civilisation has endured a number of major infectious disease outbreaks. The novel coronavirus continues its spread, infecting and killing millions of people - with no vaccine currently in sight. What can we learn from major pandemics of the past like the Black Plague, Spanish flu, Asian flu, Hong Kong flu and swine flu, as well as the ongoing global blight of HIV/AIDs? Infectious diseases, such as seasonal influenza, are more than simply public health issues; they can also have major social impacts, change economies and even alter the course of history. This book explores the health, economic and social challenges presented by the major types of infectious disease, viewed in the context of the continuing fight against the coronavirus. It compares Australia with other developed countries in relation to the effectiveness of their responses to COVID-19 through social distancing, lockdowns and other infection control measures, and also explores how vaccine-preventable disease epidemics are being successfully managed in Australia. How do we learn the lessons of history, overcome the current pandemic, and better prepare for the next deadly mass outbreak?

Body image entails a person's perception of their physical self and the positive and negative thoughts and feelings which result from that perception. Body dissatisfaction can be influenced by a complex interaction of factors ranging between individual thoughts, beliefs, feelings and behaviours regarding our own body, and our perception of the ideal body within our social and cultural environment, including on social media. In some individuals, body dissatisfaction and weight stigma can lead to debilitating physical and mental health consequences, such as eating disorders, body dysmorphic disorder, compulsive exercising, excessive dieting and cosmetic procedures. This book explores how we can better understand and accept our bodies and ourselves, offering helpful advice on how young people can build better body image. We come in all shapes and sizes, so let's celebrate our individuality and diversity.

Young Australians are disproportionately vulnerable to experiencing self-harm and suicide. Self-harm, or self-injury, is often done in secret and is most common in young people aged 11-25 years as a means of trying to cope. In Australia, suicide is the leading cause of death for males and females aged between 15 and 44; tragically, around 3,000 people in Australia each year take their own lives. For every suicide, there are ripple effects for friends, families and the wider community. We can all play a role in preventing suicide by looking out for possible warning signs, reaching out, and talking about it. This title explores risk factors, warning signs and responses to self-harming and suicidal behaviours. Prevention strategies are explained, focusing on help-seeking and enhancing protective factors. Self-harm and suicide prevention requires coordinated action from governments, health care, community workers, workplaces, schools and other educational settings, and the media, as well as individuals, families and communities. Learn how to cope, with more help and support. Young lives should be lived well.